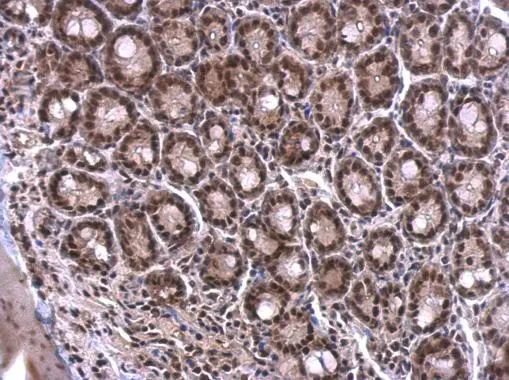
SF2 antibody detects SF2 protein at nucleus on mouse duodenum by immunohistochemical analysis. Sample: Paraffin-embedded mouse duodenum. SF2 antibody (GTX114918) dilution: 1:500. 
 Antigen Retrieval: Trilogy? (EDTA based, pH 8.0) buffer, 15min

Confocal immunofluorescence analysis (Olympus FV10i) of paraformaldehyde-fixed HeLa, using SF2(GTX114918) antibody (Green) at 1:500 dilution. Alpha-tubulin filaments were labeled with GTX11304 (Red) at 1:2000.
SF2 antibody
GTX114918
ApplicationsImmunoFluorescence, Western Blot, ImmunoCytoChemistry, ImmunoHistoChemistry, ImmunoHistoChemistry Paraffin
Product group Antibodies
ReactivityHuman, Mouse, Rat
TargetSRSF1
Overview
- SupplierGeneTex
- Product NameSF2 antibody
- Delivery Days Customer9
- Application Supplier NoteWB: 1:500-1:10000. ICC/IF: 1:100-1:1000. IHC-P: 1:100-1:1000. *Optimal dilutions/concentrations should be determined by the researcher.Not tested in other applications.
- ApplicationsImmunoFluorescence, Western Blot, ImmunoCytoChemistry, ImmunoHistoChemistry, ImmunoHistoChemistry Paraffin
- CertificationResearch Use Only
- ClonalityPolyclonal
- Concentration1 mg/ml
- ConjugateUnconjugated
- Gene ID6426
- Target nameSRSF1
- Target descriptionserine and arginine rich splicing factor 1
- Target synonymsASF, NEDFBA, SF2, SF2p33, SFRS1, SRp30a, serine/arginine-rich splicing factor 1, SR splicing factor 1, alternative-splicing factor 1, pre-mRNA-splicing factor SF2, P33 subunit, splicing factor 2, splicing factor, arginine/serine-rich, 30-KD, A
- HostRabbit
- IsotypeIgG
- Protein IDQ07955
- Protein NameSerine/arginine-rich splicing factor 1
- Scientific DescriptionThis gene encodes a member of the arginine/serine-rich splicing factor protein family, and functions in both constitutive and alternative pre-mRNA splicing. The protein binds to pre-mRNA transcripts and components of the spliceosome, and can either activate or repress splicing depending on the location of the pre-mRNA binding site. The proteins ability to activate splicing is regulated by phosphorylation and interactions with other splicing factor associated proteins. Multiple transcript variants encoding different isoforms have been found for this gene. [provided by RefSeq]
- ReactivityHuman, Mouse, Rat
- Storage Instruction-20°C or -80°C,2°C to 8°C
- UNSPSC41116161